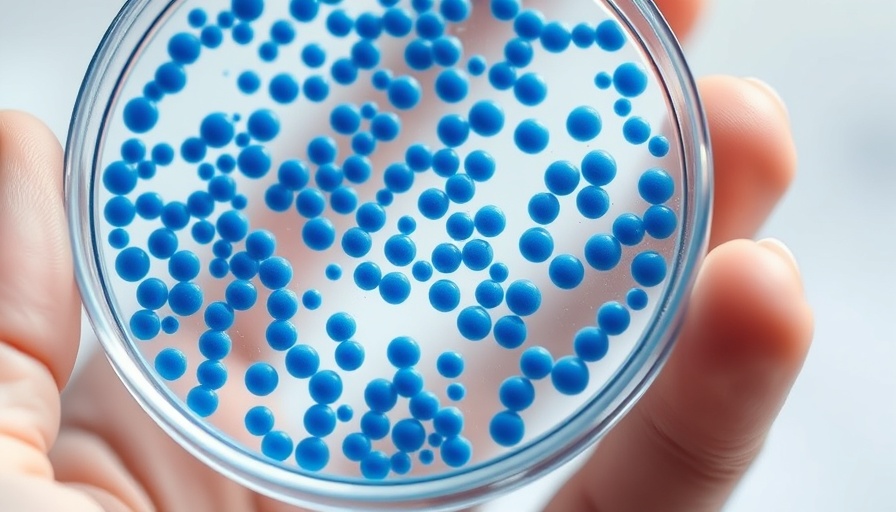

Understanding 'Nightmare Bacteria': The New Public Health Threat
In the realm of public health, terms like 'nightmare bacteria' instill fear and urgency among healthcare professionals and the general public alike. As reported by the CDC, the rate of infections caused by these elusive, drug-resistant pathogens has surged an alarming 70% since 2019. But what exactly are these nightmare bacteria, and why is their presence escalating at such a rapid pace across the United States?
The Rise of Drug Resistance
Nightmare bacteria primarily refer to two notable types of pathogens that exhibit a frightening level of resistance to antibiotics, specifically carbapenems. These are powerful antibiotics that healthcare providers usually reserve as a last line of defense. The two main culprits are Klebsiella pneumoniae and Escherichia coli, both of which can lead to serious infections. A particularly concerning variant is a strain that produces New Delhi metallo-beta-lactamase (NDM), rendering it nearly impervious to treatment. With 4,341 NDM infections reported in 2023 alone, this represents a staggering fivefold increase from previous years.
Symptom Awareness: The First Signs
Identifying infections caused by nightmare bacteria is crucial, especially since initial symptoms might resemble more common conditions. According to the CDC, symptoms include severe diarrhea, loss of appetite, and abdominal pain. Urinary tract infections (UTIs) may manifest as painful urination or cloudy urine, while bloodstream infections might be marked by a high fever and a rapid heartbeat. Understanding these symptoms could be critical for early detection and treatment.
Contributing Factors to the Surge
Several factors contribute to the alarming rise in nightmare bacteria cases. Firstly, the over-prescription and misuse of antibiotics in both healthcare settings and agriculture have accelerated the pace at which bacteria adapt and become resistant. Additionally, as more people travel internationally, exposure risks have increased, which has led to local transmission becoming a major concern. The CDC emphasizes that this is not merely a problem of imported infections but a significant domestic problem.
Future Predictions: What Lies Ahead?
As we look to the future, experts predict that the trend of increasing nightmare bacteria infections could continue unless immediate action is taken. With the emergence of new strains and resistance mechanisms, the healthcare community faces a daunting challenge. Antimicrobial stewardship is key: both healthcare providers and patients must be educated about the prudent use of antibiotics to ensure efficacy.
Protective Measures: What You Can Do
While healthcare providers play a vital role in combating the spread of nightmare bacteria, individuals can also take proactive steps. Washing hands frequently, maintaining good hygiene, and being mindful of antibiotic consumption are practical measures everyone can adopt. Moreover, staying informed about local health advisories and adhering to vaccination schedules can provide additional protection.
Actionable Insights for a Healthier Future
The news about the rise of nightmare bacteria serves as a crucial reminder of our interconnected health systems. Understanding these infections not only empowers individuals but also strengthens community health overall. Consider initiating conversations in your communities about antibiotic use and the importance of vaccinations. Engage with others to spread awareness, ultimately contributing to a more informed society that is equipped to face these challenges.
Conclusion
The increasing prevalence of nightmare bacteria is a public health wake-up call. By staying educated, adopting healthy habits, and advocating for responsible antibiotic use, we can collectively mitigate this looming threat. It's not just about protecting ourselves; it’s about looking out for one another in this shared fight against drug-resistant infections.
Write A Comment